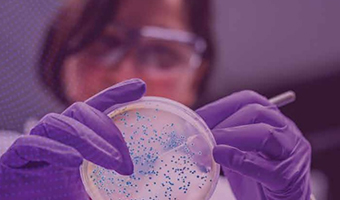

Egyptian Laboratory for Poultry Health (ELPH) was established in 1996 to undertake the
postmortem, field, and laboratory diagnosis of poultry diseases to give confirmed and approved
results for the advancement of poultry health in Egypt
Egyptian Laboratory for Poultry Health (ELPH)is one of the leading diagnostic laboratories in Egypt and the Middle East in diagnosing important epidemiological diseases that threaten poultry flocks
Egyptian Laboratory for Poultry Health (ELPH) with its competent qualified personnel, advanced equipment, modern technologies, and several branches among Egyptian provinces are matching the international guidelines and
general requirements for the competence of testing that insure accuracy, precision and response to problem diagnosis and solving

Ensuring validity of test results and prevention of cross contamination between samples as well as application of all biosafety and biosecurity best practices

1- Newcastle Disease (ND/ F-protein)
2- Highly Pathogenic Avian Influenza (H5)
3- Low Pathogenic Avian Influenza (H9)
4- Infectious Bursal Disease (IBD: Classic / VP2)
5- Infectious Bronchitis (IB: Classical / Variant)
6- Chicken Anemia Virus (CAV)
7- Reovirus
8- Mycoplasma (MG – MS)
9- Egg Drop Syndrome (EDS)


•Ensuring validity of test results and prevention of cross contamination between
samples as well as application of all biosafety and biosecurity best practices
•Bio-risk assessment to ensure it is competent to laboratory safety performs the
intended testing with appropriate risk control measures in place
•Good microbiological practices and procedures (GMPP) are followed
•Prevention of contamination, interference or adverse influences on laboratory activities
•ISO17025- certified (ongoing) within one year
•Ensuring the effectiveness of laboratory activities
•Ensure the consistent application of its laboratory activities and the validity of the
results through use of certified reference materials and standards, calibration and verification of equipment
لماذا #المعمل_المصري_لصحة_الدواجن يختلف عن باقي المعامل:- Egyptian LAB For Poultry Health - المعمل المصري لصحة الدواجن دقه.......... سرعه.......... تطوير المعمل المصري لصحة الدواجن فروعة منتشرة علي مستوي الجمهورية من أجل تقديم أسرع وأفضل وأدق الخدمات المعملية في مجال #صحة_الدواجن شاهد الفيديو مع د. هند عبد الله (مديرة المعمل المصري لصحة الدواجن - فرع الجيزة) #الدواجن
Posted by Egyptian LAB For Poultry Health - المعمل المصري لصحة الدواجن on Thursday, December 29, 2022